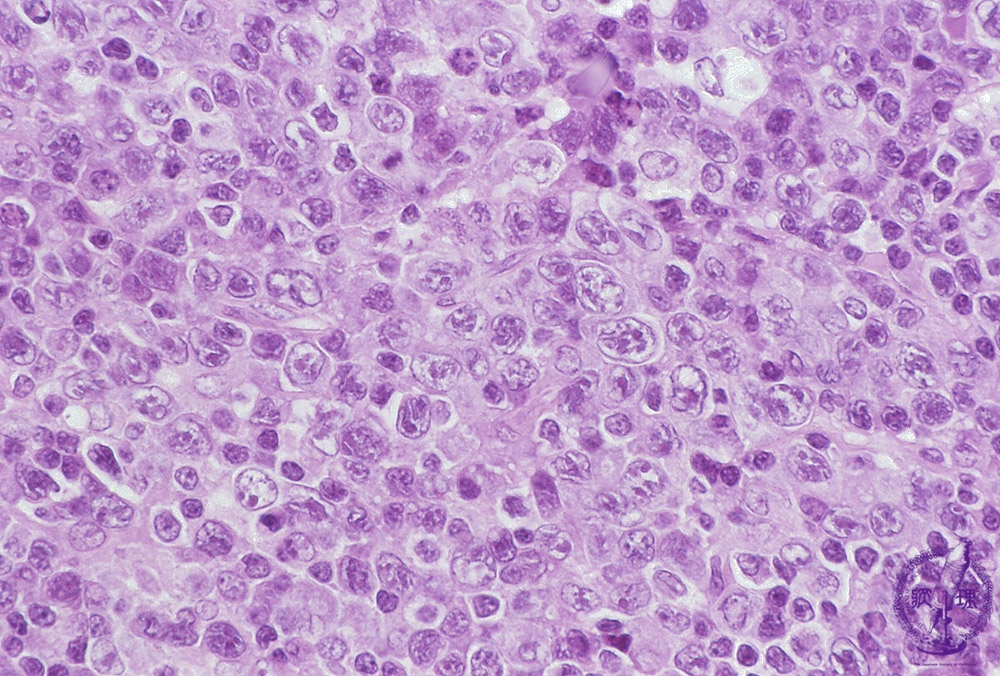
T細胞リンパ腫の病期分類

T細胞リンパ腫とは何ですか?
リンパ腫は、免疫系の白血球の一種であるリンパ球で発生するがんです。
リンパ腫は最も一般的な種類の血液がんです。これには、関与するリンパ球の特定の種類に応じて、ホジキンリンパ腫と非ホジキンリンパ腫の両方が含まれます。
非ホジキンリンパ腫は 2 つのグループに分類できます。
- B細胞リンパ腫
- T細胞リンパ腫
米国癌協会によると、
T 細胞リンパ腫にはさまざまな形態があります。治療法と一般的な見通しは、その種類と診断時の進行度によって異なります。

T細胞リンパ腫にはどのような種類がありますか?
T 細胞リンパ腫の 1 つのタイプは皮膚 T 細胞リンパ腫 (CTCL) です。 CTCL は主に皮膚に影響を与えますが、リンパ節、血液、内臓にも影響を与える可能性があります。
CTCLには主に2つのタイプがあります
その他の T 細胞リンパ腫
- 血管免疫芽球性リンパ腫。かなり攻撃的になる傾向があります。
- 未分化大細胞リンパ腫 (ALCL)。これには 3 つのサブタイプが含まれます。皮膚、リンパ節、その他の臓器に影響を与える可能性があります。
- T リンパ芽球性リンパ腫/白血病の前駆体。胸腺で発生することもあれば、肺の間の領域で増殖することもあります。
- 末梢性 T 細胞リンパ腫 – 詳細不明。これは、他のサブタイプには当てはまらない疾患のグループです。
まれなタイプの T 細胞リンパ腫
これらには次のものが含まれます。
- 成人T細胞白血病/リンパ腫
- 節外性ナチュラルキラー/T 細胞リンパ腫、鼻型
- 腸疾患関連腸管 T 細胞リンパ腫 (EATL)
- リンパ芽球性リンパ腫
- リンパ形質細胞性リンパ腫 (LPL)

T細胞リンパ腫の危険因子
非ホジキンリンパ腫のリスクを高める要因がいくつかあります。これらには次のものが含まれます。
- 年齢(50歳以上)
- 性別(男性に多く見られます)
- 免疫力の低下
- HTLV-1 ウイルスやエプスタイン・バーウイルス (EBV)によって引き起こされる感染症など

T細胞リンパ腫の症状
初期段階では病気の兆候が見られない場合もあります。症状は、T 細胞リンパ腫の特定の種類によって異なります。
菌状息肉症のいくつかの兆候と症状
- 平らで鱗状の皮膚の斑点
- 厚く盛り上がったプラーク
- 潰瘍に発展することも、しないこともある腫瘍
- かゆみ
セザリー症候群の兆候と症状
- 体の大部分、おそらくまぶたを覆う赤いかゆみのある発疹
- 爪と髪の変化
- リンパ節の肥大
- 浮腫、または腫れ
T 細胞リンパ腫のその他の考えられる兆候
すべての型の T 細胞リンパ腫が皮膚に症状を引き起こすわけではありません。他にも注意すべき点がいくつかあります。
- 出血やあざができやすい
- 再発感染症
- 原因不明の発熱や悪寒
- 倦怠感
- 脾臓の腫れによる左側の持続的な腹痛
- 腹部膨満感
- 頻尿
- 便秘

T細胞リンパ腫の発疹の写真

T細胞リンパ腫の診断
T 細胞リンパ腫を診断する場合、医師はおそらく、腫れたリンパ節などの異常な組織片から生検を採取します。
組織が切除され、検査によってリンパ腫の種類が特定されます。
T細胞リンパ腫を診断する別の方法は、血球数を測定する血液検査によるものです。この情報は、医師があなたのリンパ腫の種類、特に菌状息肉症とセザリー症候群を診断するのに役立ちます。
T細胞リンパ腫の病期分類
リンパ腫の種類を特定したら、他の検査を行って、どの段階にあるかを判断します。これは、 CT スキャンとPET スキャンによって行われます。小児がリンパ腫の診断を受けた場合、 MRI スキャンを受けることがあります。
T 細胞リンパ腫に関しては、進行期または後期で診断されることはほとんどありません。さらに、たとえ進行した段階で診断されたとしても、利用できる治療法の選択肢があります。

T細胞リンパ腫の治療
治療計画は、T 細胞リンパ腫の種類と進行度によって異なります。複数の種類の治療が必要になることは珍しいことではありません。
菌状息肉症およびセザリー症候群には、全身治療だけでなく皮膚への直接治療も含まれる場合があります。
皮膚治療
特定の軟膏、クリーム、ジェルを皮膚に直接塗布すると、症状を抑えたり、がん細胞を破壊したりすることもできます。これらの局所治療には次のようなものがあります。
- レチノイド(ビタミンA由来の薬剤)。潜在的な副作用としては、かゆみ、刺激、日光に対する過敏症などがあります。レチノイドは妊娠中に使用すべきではありません。
- コルチコステロイド。局所コルチコステロイドを長期間使用すると、皮膚が薄くなる可能性があります。
- 局所化学療法。局所化学療法の副作用には、発赤や腫れが含まれる場合があります。他の種類のがんのリスクも高める可能性があります。ただし、局所化学療法は、経口または静脈内化学療法よりも副作用が少ない傾向があります。
全身治療
T細胞リンパ腫の治療薬には、錠剤、注射、静脈内投与などがあります。標的療法と化学療法薬は、最大の効果を得るために組み合わせて使用されることがよくあります。全身治療には次のようなものがあります。
- シクロホスファミド、ヒドロキシドキソルビシン、ビンクリスチン、プレドニゾンを含むCHOPと呼ばれる化学療法の組み合わせ
- プララトレキサート(フォロチン)などの新しい化学療法薬
- ボルテゾミブ (ベルケイド)、ベリノスタット (ベレオダック)、ロミデプシン (イストダックス) などの標的薬物
- アレムツズマブ (Campath) やデニロイキン ディフティトックス (Ontak) などの免疫療法薬
進行した場合には、最長2年間の維持化学療法が必要になる場合があります。
化学療法の潜在的な副作用
光療法
UVA および UVB 光は皮膚のがん細胞を殺すことができます。光療法は通常、特殊なランプを使用して週に数回行われます。 UVA 光治療は、ソラレンと呼ばれる薬剤と組み合わせて行われます。 UVA 光はソラレンを活性化し、がん細胞を殺します。
副作用には、吐き気、皮膚や目の過敏症などがあります。紫外線は、将来的に他のがんを発症するリスクを高める可能性があります。
放射線
放射線療法は、放射性粒子を使用してがん細胞を破壊します。ビームは患部の皮膚に照射されるため、内臓は影響を受けません。放射線は一時的な皮膚の炎症や疲労を引き起こす可能性があります。
体外フォトフェレシス
これは菌状息肉症またはセザリー症候群の治療に使用されます。 2 日間の手順で、血液が除去され、紫外線と、光にさらされると活性化してがん細胞を殺す薬剤で治療されます。血液は処理後、体に戻されます。
副作用は最小限です。ただし、次のような副作用が生じる可能性があります。
- 一時的な微熱
- 吐き気
- めまい
- 皮膚の赤み
幹細胞移植
幹細胞移植は、骨髄を健康なドナーからの骨髄に置き換えることです。手術の前に、癌性骨髄を抑制するための化学療法が必要です。
合併症には次のようなものがあります。
- 移植片の失敗
- 臓器損傷
- 新しいがん

潜在的な合併症にはどのようなものがありますか?
CTCL の場合は、皮膚の問題が唯一の症状である可能性があります。どの種類のがんも、最終的には進行してリンパ節や他の内臓に影響を及ぼす可能性があります。

長期的な見通しはどうですか?
全体として、非ホジキンリンパ腫の 5 年相対生存率は次のとおりです。
他の種類のがんと同様に、医師の指示に従って経過観察することが重要です。回復と見通しは、T 細胞リンパ腫の特定の種類と診断時の段階によって異なります。他に考慮すべき点は、治療の種類、年齢、その他の健康状態です。
医師はあなたの状況を評価し、何が起こるかについてのアイデアを与えるのに最適な立場にあります。
参考文献
- https://www.cancer.org/cancer/non-hodgkin-lymphoma/detection-diagnosis-staging/factors-prognosis.html
- https://lymphoma.org/aboutlymphoma/
- https://www.medicalnewstoday.com/articles/most-common-chemo-drugs
- https://www.cancer.org/cancer/non-hodgkin-lymphoma/about/t-cell-lymphoma.html
T細胞リンパ腫を理解する・関連動画
免責事項: 健康百科事典ブログは、すべての情報が事実に基づき、包括的で最新のものであるよう努めています。しかし、この記事は、資格を持つ医療専門家の知識や専門性の代替として使用されるべきではありません。薬を服用する前には、必ず医師または他の医療専門家に相談してください。ここに記載されている情報は変更される可能性があり、すべての可能な用途、指示、注意事項、警告、薬物相互作用、アレルギー反応、副作用を網羅することを意図しているわけではありません。特定の薬物または薬物の組み合わせに関する警告や情報が記載されていない場合でも、その薬物や組み合わせがすべての患者やすべての用途において安全、有効、適切であることを意味するものではありません。
